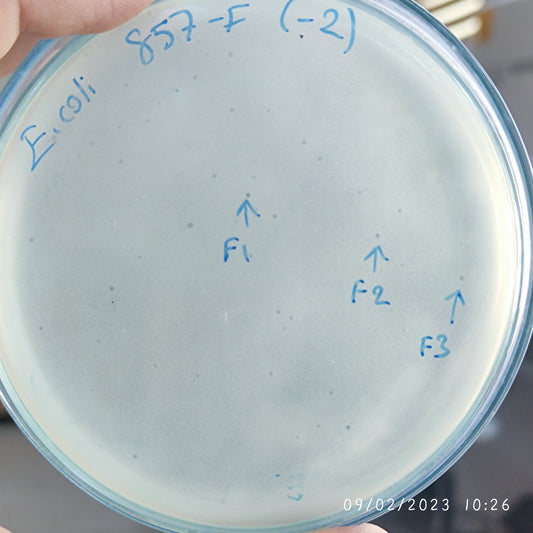
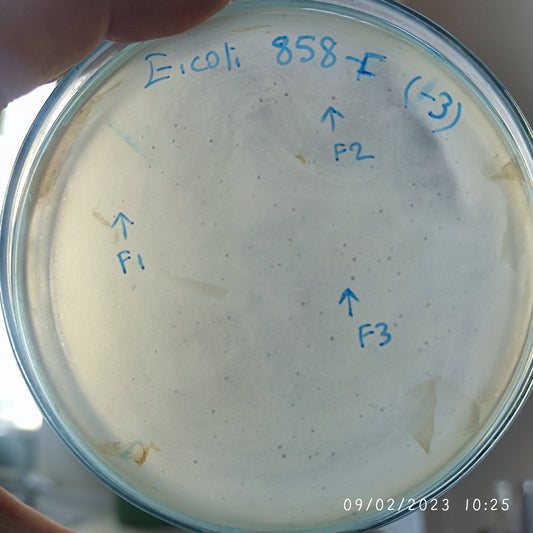
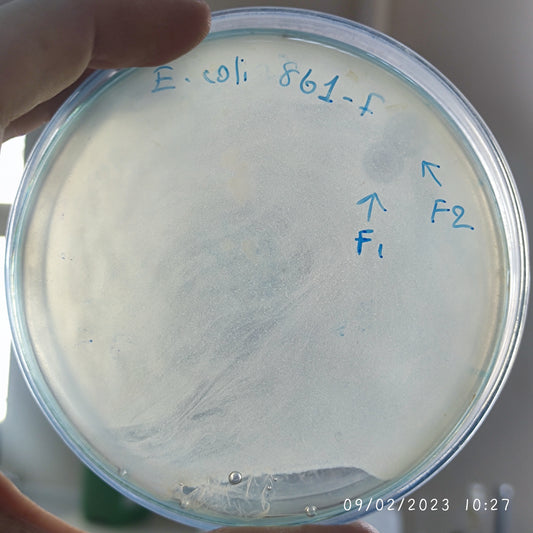
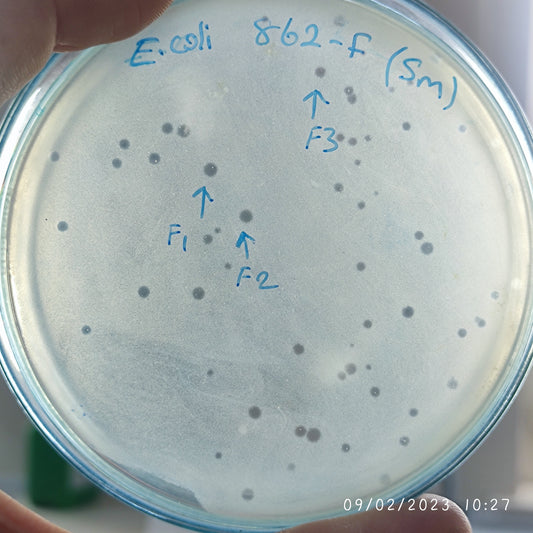
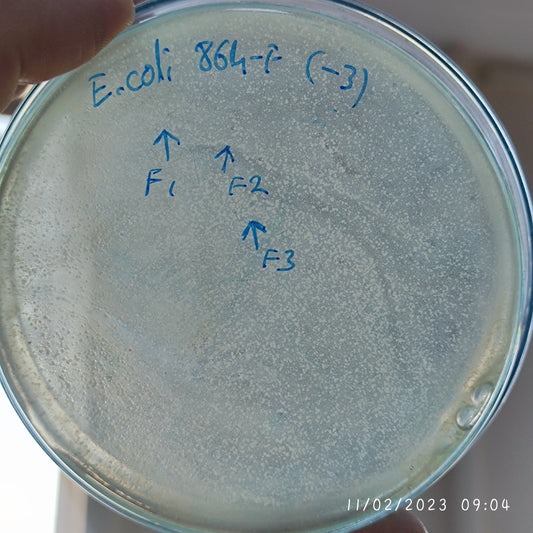
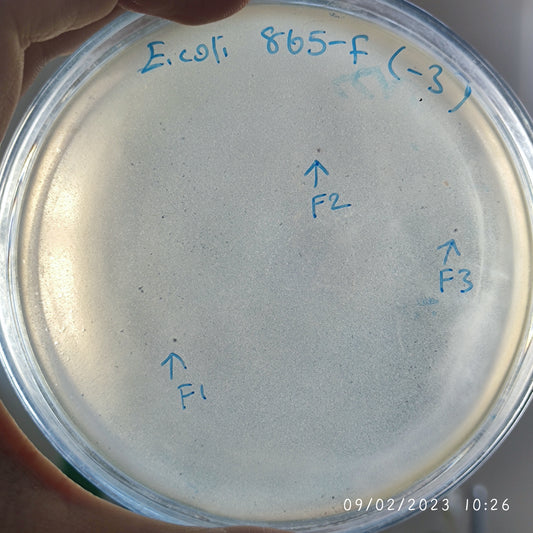
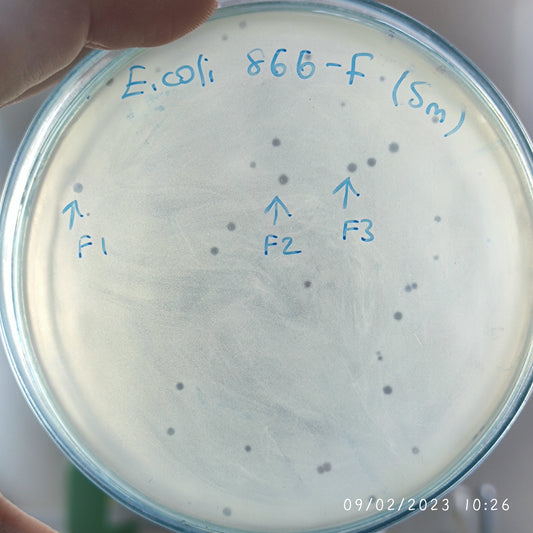
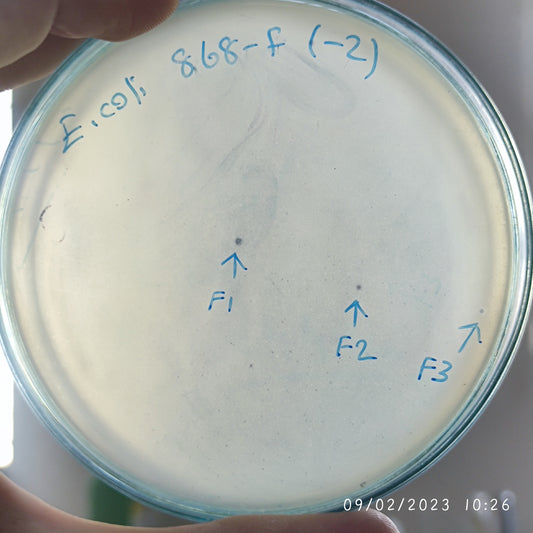
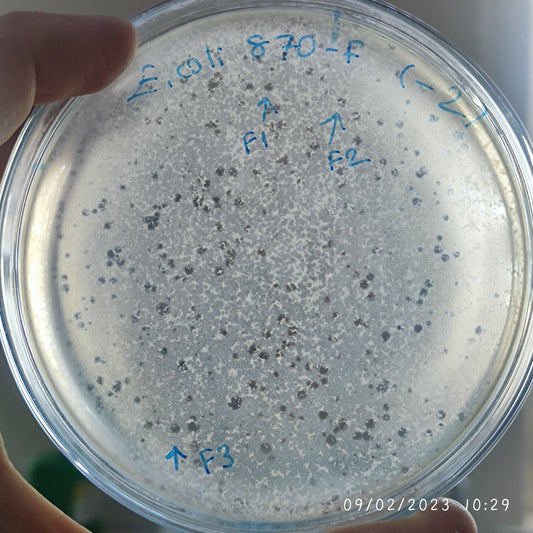
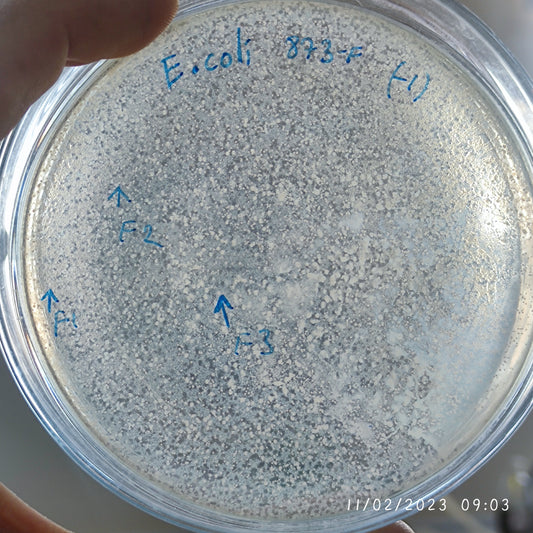
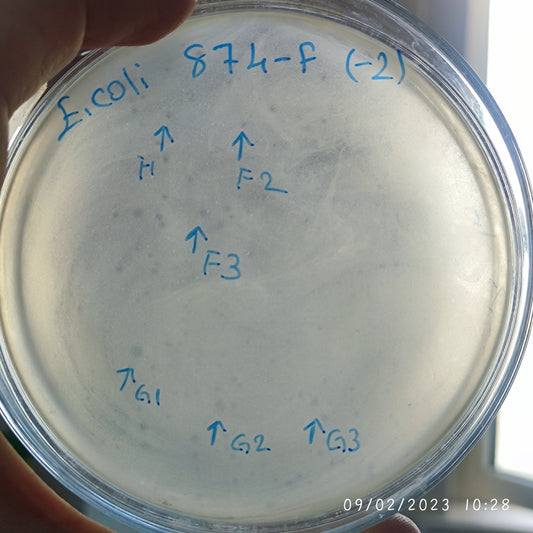

-
Escherichia coli bacteriophage 100855G
Regular price $750.00 USDRegular priceUnit price per -
Escherichia coli bacteriophage 100857F
Regular price $750.00 USDRegular priceUnit price per -
Escherichia coli bacteriophage 100858F
Regular price $750.00 USDRegular priceUnit price per -
Escherichia coli bacteriophage 100859F
Regular price $750.00 USDRegular priceUnit price per -
Escherichia coli bacteriophage 100861F
Regular price $800.00 USDRegular priceUnit price per -
Escherichia coli bacteriophage 100862F
Regular price $800.00 USDRegular priceUnit price per -
Escherichia coli bacteriophage 100863F
Regular price $600.00 USDRegular priceUnit price per -
Escherichia coli bacteriophage 100864F
Regular price $700.00 USDRegular priceUnit price per -
Escherichia coli bacteriophage 100865F
Regular price $750.00 USDRegular priceUnit price per -
Escherichia coli bacteriophage 100866F
Regular price $800.00 USDRegular priceUnit price per -
Escherichia coli bacteriophage 100868F
Regular price $800.00 USDRegular priceUnit price per -
Escherichia coli bacteriophage 100869F
Regular price $800.00 USDRegular priceUnit price per -
Escherichia coli bacteriophage 100870F
Regular price $750.00 USDRegular priceUnit price per -
Escherichia coli bacteriophage 100872F
Regular price $600.00 USDRegular priceUnit price per -
Escherichia coli bacteriophage 100873F
Regular price $600.00 USDRegular priceUnit price per -
Escherichia coli bacteriophage 100874F
Regular price $600.00 USDRegular priceUnit price per